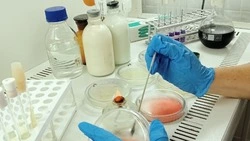

#лаборатория
Лучшее за


Врио губернатора Александр Шуваев сообщил о передачи документов в областную избирательную комиссию
30 июня , 11:43


Врио губернатора Александр Шуваев посетил Ракитянский округ
1 июля , 11:00


Суд вынес ракитянцу приговор за вождение автомобиля в нетрезвом состоянии
28 июня , 14:00


Ракитянский и Краснояружский округа вновь были атакованы
1 июля , 13:32


Краснояруженка вошла в число победителей межрегионального конкурса «Три ратных поля России
28 июня , 14:00
Все материалы
Последние новости
Все новости